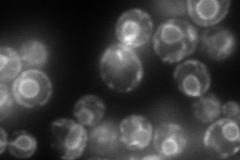
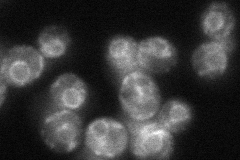
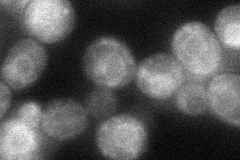
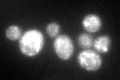

View description
Subunit of the Ssh1 translocon complex; Sec61p homolog involved in co-translational pathway of protein translocation; not essential
Localization:
Intensity:
Fold change:
Significance:
-
C’ GFP library in SD

ER84.73 -
N' NOP1pr-GFP in SD
ER207.321 -
N' TEF2pr-mCherry in SD

ER243.876 -
N' NATIVEpr-GFP in SD
ER45.1144 -
N' TEF2pr-VC and Cyto-VN in SD
ER46.8449 -
C’ GFP library in SD+DTT
ER66.880.78No -
C’ GFP library in SD+H2O2

ER104.561.23No -
C’ GFP library in Starvation Media

ER67.620.79No -
C’ GFP library on the background of Pup2-DaMP

ER -
C’ GFP library on the background of CCT mutant

ER96.1551.13465No
